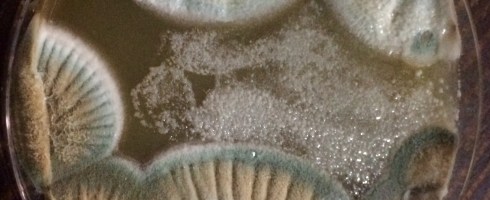

I have just been prompted to step back and think about what we are doing… as I listened to that speech by Jesse Williams.
I want to say this as a long time activist and conscious Boricua who isn’t so active anymore. I also say it as the brewmaster of this group of cervezistas who are ramping up our beer brewing to our original recipes. In a funny way, the fact of us brewing this beer is an act of liberation!
Why do I say that? First, in making a beverage that has walked side by side with the development of civilization, we are taking part of a long, noble and honorable tradition of our human species. We are making a drink that, at its best, lubricates the intermeshing parts of the great social organism.
BUT its of note the reaction that people, our people… have to the fact of us actually making something that is such a commonplace component of their lives. Someone they have encountered is not just a consumer, but a producer!! It reminds me of the reaction that people have had to my line of business. It inspires a brief flicker of…. surprise, shock and maybe even a chin chin of awe. Funny that!
Whether we are deserving of that reaction or not, it says something to me about people seeing someone having agency..Its always a positive response..its a gladness of agency…someone in my sphere has agency in this crazy area.
So yes, in this small way, we are claiming our agency in the world… to make BEER! This whole little discussion has a smell to me something of an oxymoron….hey Jose! You’re putting all this import upon this paltry, crass, working man’s drink. Yeah, while I hear that, I try to educate everyone who will listen about the true ancient, revered, significant and honorable tradition of brewing. Fermented beverages are a truly global human practice. In many ways, we are all children of the microscopic fungus that is Saccharomyces Cerevisiae. But that is the subject of another post.
If you take my word for it, our small band of cervezistas are joining into the global phenomena of home – craft -brewing. However, we are not just trying to make one of the many thousands of beers out there. We have a different objective… we are trying to be creative by drawing from the roots of our Caribbean culture to carve out a space in the brewing scene from which we Boricuas, Latinos People of color, like so many other endeavors, are absent. We are trying to connect to the homeland in a concrete material way to affirm our identity and existence! So you could say that our beer is an act of cultural affirmation!
Not only that, but we are trying to support an cultural / economic institution, Camaradas, that brings our people together in the best tradition of pubs and drinking holes in the Western world. We want to add to it, enhance it, expand it.
One important role for Liberation is freeing us from all the inner burdens that make us smaller, lesser, more limited, more modest, minor, less ambitious, audacious or rigorous. I reject this and in so doing, we are keeping ourselves to standards of excellence…. to aspire to high benchmarks in what we make and but also in what we expect of each other. No half-stepping. We won’t be half assed, slow moving, sloppy and inefficient. In fact, I had a conversation recently with someone who heard my struggles to get things right asking …. “so you’re striving for excellence huh?”. That struck me…like oh, what a novelty! So yes, excellence.
Excellence right here in El Barrio in NYC by slowly building to be solid, kickass and creative based on cooperation and collaboration! We are trying to economically develop an institution and our community….We are pooling resources and utilizing all of our respective training and abilities to move forward.
I am very aware that we are doing this as our people suffer on the island economically, politically and psychologically. Many of us mainland Boricuas look upon that situation and ache in our hearts… I know the thoughts are never far away in my head….”How come we’re always in trouble?”. That little haunting voice that’s frequently lurking in my head wondering about us….”is it true..?” I have no better example than what my beloved Abuela used to tell me …. “Los Puertoriquenos son uno “good time Charlies” …no le gustan trabajar…solo gustan fiestar”. I would wager that as the mark the oppression has on us all!!
Its for that voice, that I’d guess that many of us share, that we have calendars and such to celebrate those of us that achieve…these tokens are like a cultural garlic to ward away the blood sucking messages of internalized oppression we have way much too much of. We all “know” that we need to show mostly each other, our people (and the world) that we can do something and it can be great!
So to build our small endeavor, I am hard on my crew to get things right. I am unrelenting and undoubtedly exasperating, annoying and surely crazy-making. I may be hard on everyone…..but I do so to not give in to the weakening voices accepting us as less, the internalization of a meager place in the world. I am hard to urge us forward, to aspire, to dream, to create, to cooperate, to push us … dare I say, to greatness.
In my eyes, us Cervezistas can be an example of being creators and innovators! We have to do it, as much as possible, with fun, joy, good will and sharing. I see us as taking our desire to “fiestar” and turning into trabajar y crear. Aside from this inadvertent bad rhyming, this is our task, to battle for our selves on many fronts in this life as it manifests itself in early 21st century capitalism in NYC and in the island. In this struggle, all we have in the end is each other! For us, its to do the most unlikely of things…to make beer!